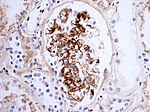

Medical kidney diseases
This article describes medical renal disease or the medical kidney. Much in medical kidney depends on the clinical information. Most of the disease seen by pathologists is... glomerular disease. It is one of the few areas that routinely requires electron microscopy.
Medical kidney is niche area in pathology. In the context of exams for general pathologists, if in doubt... the answer to most questions is diabetes mellitus or systemic lupus erythematosus.
Kidney tumours are dealt with in the kidney tumours article, and pediatric kidney tumours article.
Clinical
Creatinine
- The standard screening test for renal function.
- 300 mmol/L is the general cut-point for referral to a nephrologist.[1]
Notes:
- In some parts of the world they use the units mg/dL; normal with these units is: 0.8 to 1.4 mg/dL.[2]
- Conversion: 1.0 mg/dL = 88.4 umol/L.[3][4]
Glomerular filtration rate
- Abbreviated GFR.
- Ultimate measure of renal function - usually estimated from the serum creatinine using a formula.
- Declines with age.
- Normal range (dependent on age): 116-75 mL/min/1.73m2.[5]
Urine protein to creatinine ratio
- Indicator of proteinuria.
- Predictor of glomerular filtration rate.[6]
Cut points:[7]
- Normal (2 years and older): <0.2 g protein / g Creatinine
- Nephrotic range: >3.5 g protein / g Creatinine.
Complement
C3, C4 levels:[8]
- Changed:
- Systemic lupus erythematosus (SLE); levels decreased = increased disease activity.
- Post-infectious GN - decreased.
- MPGN - decreased. (???)
- Infection.[9][10]
- Hemolytic anemia.[9][11]
- Normal:
- Minimal change disease.
- Chronic pyelonephritis.
- Renal vein thrombosis.
- Amyloidosis.
ANCA
Types:[12]
- MPO-ANCA (myeloperoxidase antineutrophil cytoplasmic autoantibody).
- Previously p-ANCA.
- Seen in ANCA-vasculitides, esp. microscopic polyangiitis.
- PR3-ANCA (proteinase 3 antineutrophil cytoplasmic autoantibody).
- Previously c-ANCA.
- Seen in ANCA-vasculitides, esp. granulomatosis with polyangiitis (Wegener granulomatosis).
C4d
- Suggests humoral immunity (antibody-mediated immunity) at play.
- Important in monitoring of renal transplant recipients.
- Immunostain also available - see below.
Other blood work
- ANA, dsDNA -- to screen for systemic lupus erythematosus.
- Hepatitis B.
- Hepatitis C.
- HIV.
- Serum protein electrophoresis (SPEP) -- to screen for plasma cell neoplasms.
- Often done together with urine protein electrophoresis (UPEP).
Renal ultrasound
- Normal adult kidney size ~10.8+/-0.8 cm.[13]
- Good for assessing the major vessels, drainage system and parenchymal lesions.
- Renal artery stenosis?
- Hydronephrosis?
- Pelviectasis?
- Renal cyst?
- Renal mass?
Urine dip
Findings:[14]
- RBC casts = acute bleed, e.g. nephritic syndrome.
- WBC casts = interstitial nephritis, e.g. pylonephritis, parenchymal infection.
- Hemegranular casts = acute tubular necrosis, transplant rejection.
Notes:
- "Active sediment" = RBCs, RBC casts;[15] implies glomerulonephritis.
- Some include the above (RBCs, RBC casts) + WBCs & protein.[16]
Urine crystals
Clinical presentations
Nephrotic syndrome
Features:
- Anasarca (whole body - edema).
- Proteinuria (>3.5 g/24h).
- Hypercholesterolemia.
- Hypoalbuminemia.
Nephritic syndrome
Features - mnemonic PHAROH:[17]
- Proteinuria.
- Hypertension.
- Azotemia.
- RBC casts.
- Oliguria.
- Hematuria.
Mixed
- Features of nephritic syndrome and nephrotic syndrome.
Clinical DDx
Renal failure 101
- Prerenal.
- Shock - cardiogenic, hypovolemic, neurogenic, septic, anaphylatic.
- Renal.
- What this article deals with.
- Postrenal.
- Outflow obstruction, e.g. prostatic nodular hyperplasia (AKA BPH).
Renal causes
- Isolated hematuria.
- Isolated proteinuria.
- Nephrotic syndrome.
- Nephritis syndrome.
- Rapidly progressive glomerulonephritis.
- Chronic renal failure.
- A combination of any of the above.
The clinical presentations suggest a pathologic DDx.[18]
Isolated hematuria
Proteinuria
- Diabetic nephropathy.
- Classic causes of nephrotic syndrome:
- Paraprotein-related:
- Renal amyloidosis.
- Monoclonal immunoglobulin deposition disease (MIDD).
- Weird stuff:
Nephritic syndrome
Classic:
- Post-infectious glomerulonephritis.
- Classically streptococcal.
- Crescentic glomerulonephritis (AKA rapidly progressive glomerulonephritis (RPGN)).
Others:
Rapidly progressive glomerulonephritis
Classification:[20]
- Linear immune deposits.
- Antiglomerular basement membrane disease & Goodpasture's syndrome.
- Granular immune deposits.
- Immune complex diseases.
- Systemic lupus erythematosus.
- IgA nephropathy.
- Others.
- Immune complex diseases.
- Pauci-immune.
- ANCA vasculitides.
Nephrotic syndrome
- Minimal segmental disease (MSD) - AKA minimal change disease (MCD).
- Focal segmental glomerulosclerosis (FSGS).
- Membranous nephropathy.
Mixed presentation
- IgA nephropathy.
- Focal proliferative glomerulosclerosis (FPGS).
- Membranoproliferative glomerulonephritis (MPGN).
Normal kidney
Cells of the glomerulus
- Podocytes.
- Mesangial cells.
- Endothelium.
Epithelium
Features:[21]
- The glomeruli visceral epithelium is part of the capillary wall (part of the glomerular tuft).
- The parietal epithelium is part of Bowman's capsule.
Remember: visceral has vessels.
Glomerulus
- A large autopsy series suggest it is: 223-292 micrometers.[22]
- Another autopsy series suggests the mean diameter is: 225 micrometers.[23]
Note:
- If the glomerulus fills half the field at 40x on a microscope with 22 mm diameter eye pieces it is ~ 0.275 mm or 275 micrometers.
Glomerular basement membrane
The glomerular basement membrane (GBM) should be thinner than the tubular basement membrane.
Images
Basic approach to renal biopsy
Basic components
- Glomeruli.
- Tubules.
- Interstitium.
- Vessels.
Memory device GI TV: glomeruli, interstitium, tubules, vessels.
Glomeruli
- Mesangium
- Matrix should be: "one cell thick" (expanded in diabetes mellitus).
- Cellularity of the mesangium - normal = upto 3 cells (don't count cell abutting the capillary lumen, don't count at the hilum).
- Capillary loops "open"
- Lumina patent? If not patent is it due to matrix or cells (endocapillary hypercellularity).
- Capillary wall morphology - wavy thin is normal; hulla-hoop/wire-like abnormal (suggestive of immune complex deposition).
- Bowman's space (urinary space) - crescents present?
- Count the number of glomeruli.
- Count number of the obsolete glomeruli.
Notes:
- Endocapillary hypercellularity has a DDx - it includes: IgA nephropathy,[24] and lupus nephritis.[25]
Components of the glomeruli (anatomical)
- Podocyte - rarely affect by disease
- One notable disease is collapsing glomerulopathy in HIV.[26]
- Endothelial cell.
- Mesangial cell.
Obsolete glomeruli
- Completely sclerosed glomeruli are not important - unless present in larger numbers than expected for the age of the patient.
- Percent of sclerosed glomeruli = (age in years)/2 - 10%.[27]
Example:
- It is normal for an 80 year-old to have 30% sclerosed glomeruli.
Glomerular disease terms
Number of glomeruli involved:[28]
- Focal = some of the glomeruli.
- In practical terms, defined as: <50% of glomeruli.
- Diffuse = most of glomeruli.
How much of the glomerulus is involved:[28]
- Global = most of the glomerulus.
- In practical terms, defined as: >80% of glomerulus.[29]
- Segmental = part of the glomerulus.
Vessels
- Arteriolar hyalinosis - too much glassy pink stuff?
- Intimal hyperplasia (atherosclerosis).
Consider:
- Vasculitis? - inflammatory cells in vessel wall.
- Amyloid? - pink.
- Rejection? - PMNs.
- Cholesterol emboli?
Arteriolar hyalinosis
Microscopic:
- Small vessels (afferent +/- efferent arteriole) with:
- Glassy eosinophilic material in arteriolar wall.
- PAS stain +ve.
- Glassy eosinophilic material in arteriolar wall.
DDx:
- Aging.
- Diabetes mellitus.
- Hypertension.
- Drugs - calcineurin inhibitors (tacrolimus, cyclosporine).
Note:
- Arteriolar hyalinosis - involves afferent and efferent arterioles in diabetes, in others it is only the afferent.
Memory device ADHD:
- Aging, Diabetes, Hypertension, Drugs.
Image
Atherosclerosis
Microscopic:
- Intimal thickening of medium-sized vessels.
- Where is the intima/media interface?
- Internal elastic lamina - wavy band of eosinophilic material on H&E that is 1-2 micrometres thick.
- Where is the intima/media interface?
Grading - based on the thickness of the media and intima:
- Mild: (tunica) media > (tunica) intima.
- Moderate: media = intima.
- Severe: media < intima.
Tubules
Tubules - proximal portion is the most important.
Consider:
- Casts?
- Degeneration, i.e. apoptosis.
- Necrosis?
- Regeneration, e.g. mitoses.
Interstitium
Interstitium
- Fibrosis - prognostically important.
- Grading: mild = <25%, moderate 25-50%, severe >50%.
- Inflammation?
Staining
The standard stain in kidney pathology is PAS. Section are usually 1-2 micrometers, as opposed to 4-5 micrometers seen in rountine section of other organs.
Interpretation of medical renal disease more difficult or even impossible if the sections are thicker, as one does not see the glomerular structures well.
In kidney that is cut thick the glomeruli look more nodular and it is more difficult to find open capillary loops.
Immunofluorescence
Routinue (mnemonic GAM CF):
- IgG.
- IgA.
- IgM.
- C1q
- C3.
- Fibrinogen.
- Albumin.
Optional:
- Kappa.
- Lambda.
- C4d.
- Positive staining = peri-tubular capillaries stain.
Negative immunofluorescence
- Excludes all immune complex associated disease.
Seen in:
Positive immunofluorescence
- Positive immunofluorescence is usually diagnostic.
Basic patterns:
- Linear.
- Granular.
- Ring-like.
Examples:
- Linear IgG:
- Granular deposits:
- "Full house" - all present.
- Branching IgA.
- IgG, C3, kappa, lambda.
- Linear C3 with mesangial rings; IgG -ve, IgA -ve.
- Dense deposit disease (DDD).
Notes:
- Nonspecific linear IgG staining may be seen in diabetic nephropathy.
Can be:
- Subepithelial - distal to basement membrane (BM), closer to the urinary space.
- Membranous nephropathy, Post-infectious glomerulonephritis (hump-like), MPGN.
- Subendothelial - proximal to BM, closer to the glomerular capillary.
- MPGN - classic location.
Pathologic differential diagnosis
Tram-tracking of BM
DDx:[30]
- MPGN.
- Thrombotic microangiopathy (TMA).
- Transplant glomerulopathy (TG).
Mesangial hypercellularity
DDx:
Mesangial expansion
- A patch of matrix can contain more than three mesangial cell nuclei.
- Highly subjective.
DDx:
- Diabetes mellitus.[31]
- MPGN:
- Fibrillary glomerulopathy.
- Immunotactoid glomerulopathy.
- Renal amyloidosis.
- Monoclonal immunoglobulin deposition disease.
Glomerular crescents
- AKA crescents.
General
- Indicates a rapidly progressive disease.
- Etiology/definition: break in the glomerular basement membrane (GBM).
Microscopic
Features:
- Crescentic-shaped lesion in the urinary space of a glomerulus.
- Crescent = looks like the moon shortly after new moon.
- Cells & cellular debris in the urinary space.
- Crescents lack GBM -- thus PAS -ve and MPAS -ve.
- Break in the glomerular basement membrane - key feature.
- Best seen on a silver stain (e.g. Jones stain).
- Fibrin.
- Inflammatory cells (lymphocytes, plasma cells, eosinophils, macrophages) - extravascular - low power feature.
DDx:
- Glomerular sclerosis:
- GBM visible through-out glomerulus.
- No fibrin.
- Collagen deposition within the glomerular tuft.
- Seen with trichrome stain.
- +/-Glomerular tuft-capsule adhesions.
- +/-Glomerular enlargement.
- Usu. no significant inflammation.
Bland necrotic crescents
DDx:
- ANCA-related glomerulonephritis.
- Anti-GBM disease.
Diseases with crescents - is a long list.[32]
Primary light microscopy patterns
| Pattern | Key feature | Other findings | DDx of the pattern | DDx | Image |
|---|---|---|---|---|---|
| Normal light microscopy | Normal histology | none or few glomeruli in a biopsy of an under sampled FSGS | membranous nephropathy, focal segmental glomerulosclerosis (FSGS) | normal kidney, minimal change disease, thin glomerular basement membrane disease, Alport syndrome, early membranous nephropathy | |
| Nodular mesangial expansion | nodular mesangial matrix expansion, no mesangial hypercellularity | GBM thickening, both afferent and efferent arteriole hyalinized | diffuse proliferative GN, membranous nephropathy | diabetic nephropathy, idiopathic nodular glomerulosclerosis, renal amyloidosis, light chain deposition disease, fibrillary glomerulopathy, immunotactoid glomerulopathy | |
| Membranous nephropathy (MN) | GBM spikes or pinholes with silver stain, GBM thickening on PAS | +/-mesangial hypercellularity +/-tram-tracking/wireloop GBM | normal light microscopy, light chain deposition disease | hepatitis B, hepatitis C, carcinoma, NSAID toxicity, SLE, idiopathic (MN); light chain deposition disease (plasma cell neoplasm) | |
| Focal segmental glomerulosclerosis | sclerosed glomeruli = mesangial expansion with collagen | +/-glomerular enlargement, +/- tuft-capsule adhesions | rapidly progressive glomerulonephritis, nodular mesangial expansion | primary FSGS, secondary FSGS (HIV, IVDU, obesity, parvovirus B19, Alport syndrome | |
| Diffuse proliferative glomerulonephritis | mesangial hypercellularity | +/-mesangial expansion, +/-interstitial inflammation | nodular glomerulosclerosis | post-infectious glomerulonephritis, MPGN, dense deposit disease, diffuse proliferative lupus nephritis (class IV), cryoglobulinemic GN | |
| Rapidly progressive glomerulonephritis | glomerular crescents | +/-inflammation, +/-vasculitis | FSGS, diffuse proliferative glomerulonephritis | AGBM, post-infectious glomerulonephritis, pauci-immune GN, immune complex diseases (lupus nephritis, IgA nephropathy, others) | |
| Tubular injury | tubular degeneration (loss of cilia in proximal tubule, apoptosis, necrosis), regeneration (mitosis, nucleoli) | +/-interstitial fibrosis | normal light microscopy | acute tubular necrosis, chronic allograft nephropathy | |
| Small vessel pathology | luminal narrowing; +/-thrombosis, +/-hyalinosis | +/-onion-skinning | none | thrombotic microangiopathy (malignant hypertension, scleroderma renal crisis, DIC, HUS, TTP, | |
| Large vessel pathology | luminal narrowing or obstruction; +/-intimal thickening; +/-embolization | +/-medial thinning | none | atherosclerosis, cholesterol embolism, other types of embolism, thrombosis |
Diagnoses - Table
| Pattern | Key feature | Other findings | IF & EM | Presentation | Clinical | Pathol. DDx | Image |
|---|---|---|---|---|---|---|---|
| Nodular glomerulosclerosis | nodular mesangial matrix expansion | GBM thickening, both afferent and efferent arteriole hyalinized | EM? | proteinuria - typical presentation, nephrotic syndrome[citation needed] | diabetes mellitus (DM) | amyloidosis, idiopathic nodular glomerulosclerosis (nodular GS without DM) | |
| Focal segmental glomerulosclerosis (FSGS) | focal sclerosis of gloms | +/-interstitial fibrosis | IF: negative; EM: foot process loss | nephrotic syndrome | primary FSGS, secondary FSGS (HIV, IVDU, obesity, parvovirus B19, Alport syndrome); unresponsive to steroids, worse prognosis than MCD | minimal change disease | |
| Membranous nephropathy (AKA membranous GN) |
spikes or pinholes with silver stain | mesangial hypercellularity; +/-tram-tracking/wireloop GBM | IF: diffuse granular capillary loop IgG, C3, kappa, lambda; EM: diffuse subepithelial deposits - spike forming | nephrotic syndrome | hepatitis B, hepatitis C, carcinoma, NSAID toxicity, SLE, idiopathic | Nodular glomerulosclerosis (?) | |
| Minimal change disease (MCD) | foot process loss on EM | usu. none | EM: foot process loss | nephrotic syndrome | primary vs. secondary (lymphoproliferative disorder, NSAIDs); idiopathic responds to steroids | FSGS, thin glomerular basement membrane disease (histologic DDx) | Image? |
| IgA nephropathy | IgA branching pattern | +/-mesangial hypercellularity, +/-crescents | IF: IgA +ve (branching pattern); EM: dense mesangial deposits | mixed nephrotic/nephritic | primary vs. secondary (Henoch-Schoenlein purpura) | RPGN | |
| Membranoproliferative glomerulonephritis (MPGN) | thick GBM | Other findings? | subepithelial deposits | mixed nephrotic/nephritic | SLE, cryoglobulinemia, hepatitis B, hepatitis C | Pathol. DDx? | |
| Focal proliferative glomerosclerosis (FPGS) |
<50% of glomeruli partially sclerosis | Other findings? | EM? | mixed nephrotic/nephritic | Clinical? | Pathol. DDx? | Image? |
| Rapidly progressive GN (RPGN) | crescents | Other findings? | EM? | nephritic syndrome | AGBM, ANCA-vasculitis | IgA nephropathy with crescents | Image? |
| Dense deposit disease | IF: linear C3 with rings | +/-thick GBM | EM: GBM lamina densa thickening | Presentation? | mixed nephrotic/nephritic (???) | MPGN | (nature.com) |
Diffuse proliferative glomerulonephritis
| Pattern | Key feature | Clinical |
|---|---|---|
| Post-infectious glomerulonephritis | IF: capillary loop +/- mesangial IgG/C3; EM: large infreq. hump-like subepithelial deposits | post-infection |
| Membranoproliferative glomerulonephritis (MPGN) | mesangial proliferation with thickening of the glomerular capillary loops[33] | low C3, normal C4; primary vs. secondary (often hepatitis C) |
| Dense deposit disease | IF: linear C3 with rings | |
| Cryoglobulinemic glomerulonephritis | ||
| Diffuse proliferative lupus glomerulonephritis | systemic lupus erythematosus; low C3, low C4 | |
| Diffuse proliferative IgA nephropathy | IF: IgA +ve (branching pattern) |
Common diseases
Diabetic nephropathy
General
- Due to diabetes mellitus - key feature.
- If there is no history of diabetes... it is idiopathic nodular glomerulosclerosis.
- Most common cause of end-stage renal disease (ESRD).
- Biopsied only if the (clinical) features are atypical.
Microscopic
Features:[34]
- Thick glomerular basement membrane (GBM).
- Thickened (eosinophilic) tunica media in both the afferent and efferent arterioles.[35]
- Mesangial matrix expansion - leads to nodule formation Kimmelstiel-Wilson nodules (nodular glomerulosclerosis).
Others:
- Armanni-Ebstein change = cytoplasmic vacuolization of tubular cells (usu. loop of Henle) -- innermost cortex, outer medulla;[36] not specific to diabetes mellitus.[37]
- Capsular drop = hyaline material deposited in the Bowman's capsule.[38]
- Fibrin cap = subendothelial deposition of hyaline material.[38]
Other - with weak evidence:
- Extra efferent vessels.[39]
Memory device:
- GBM = thick GBM, both afferent & efferent arterioles thickened, mesangial matrix expansion.
Images
www:
Notes:
- Hypertensive kidneys have changes only in the afferent arteriole, i.e. the efferent arteriole is spared (see hypertension).
Grading
The severity of changes can be indicated by the grade:[40]
| Grade | Criteria |
|---|---|
| Grade I | GBM thickening on EM only |
| Grade II | Mild-to-moderate mesangial expansion only on LM |
| Grade III | Glomerulus with mesangial nodules (Kimmelstiel–Wilson nodules) |
| Grade IV | Stage III + global sclerosis in >50% of glomeruli |
IF
- Negative.
- +/-Nonspecific linear IgG.
EM
- Severe thickening of GBM.
- Mesangial sclerosis.
Lupus nephritis
- Abbreviated LN.
General
- Bread & butter of nephropathology.
- The biopsy is done to determine treatment, i.e. how much immunosuppression is needed.
Immunofluorescence
- "Full house" = all of 'em light up.
Classification
International Society of Nephrology/Renal Pathology Society (ISN/RPS) classification:[41][42]
- Class I - minimal mesangial LN.
- Class II - mesangial proliferative LN.
- Mesangial hypercellularity. (???)
- Class III - focal lupus nephritis; <50% of glomeruli.
- Mesangial hypercellularity. (???)
- Class VI-S - diffuse segmental LN; >50% of glomeruli.
- Mesangial hypercellularity. (???)
- Class VI-G - global LN; >50% of glomeruli.
- Class V - Membranous lupus nephritis.
- Membranous nephropathy due to SLE.
- Class IV - Advanced sclerosing LN; essentially end-stage kidney.
Notes:
- Most of the action is in Class III and Class IV.
- Class I is near normal - doesn't get biopsied.
- Class IV is essentially a dead kidney - doesn't get biopsied.
Images
- Membranous lupus:
Nephrotic syndrome
This classically includes the following:
It also includes:
- IgA nephropathy.
- Pre-eclampsia - uncommon.[43]
Mixed nephrotic and nephritic
IgA nephropathy
- AKA Berger disease.
- Should not be confused with Buerger disease (thromboangiitis obliterans).
General
- More common in Asians.
- Associated with an increased incidence of Celiac disease.[44]
- IgA nephropathy, in children, with a skin rash (leukocytoclastic vasculitis) = Henoch–Schönlein purpura.
- May present as nephrotic syndrome.[45][46]
- May present as isolated hematuria.[19]
Microscopic
Features:
- Variable:
- Mesangial hypercellularity - may be only light microscopy finding.
Note:
- Diagnosis based on immunofluorescence (IgA+).
Images
Scoring
IgA nephropathy can be scored using an assessment of mesangial proliferation, endocapillary proliferation, glomerulosclerosis and tubular atrophy and interstitial fibrosis (abbreviated MEST).[47]
IF
- IgA +ve in a branching pattern - diagnostic.
EM
- Mesangial deposits.
- These are electron dense, ergo dark on EM images.
Membranoproliferative glomerulonephritis
- Abbreviated MPGN.
- Old name MPGN type 1.
General
Clinical:
- Nephrotic syndrome or nephrotic/nephritic syndrome.
Pathology:
- May be primary, i.e. idiopathic, or secondary, i.e. a consequence of another pathologic process.[33]
Secondary causes
- In adults most common cause: hepatitis C.
Other causes:
- HIV.[48]
- SLE - usu. has "full house" on IF.[33]
- Cryoglobulinemia.
- Hepatitis B.
- Portocaval shunt.[48]
Microscopic
Features:
- Endothelial cell proliferation.
- Basement membrane double layering (tram-tracking).
- Mesangial hypercellularity.
DDx:
Images
EM
Features:
- Subendothelial immune deposits - classic finding.[49]
- Subepithelial immune deposits - historically considered uncommon.[50]
Dense deposit disease
- Abbreviated DDD.
- AKA MPGN type 2 (old name).
General
- Usually children and young adults.
- No longer considered a type of MPGN.[51]
Microscopic
Features:
- Variable - may be like MPGN.
- Four patterns:[51]
- Hypercellularity and lobular (membranoproliferative-like).
- Mesangial proliferative.
- Crescentic.
- Acute proliferative and exudative.
- Four patterns:[51]
Images:
IF
- Linear C3 with mesangial rings (donut-like).
- IgG negative.
- IgA negative
Images:
EM
- Electron dense transformation of GBM lamina densa - key feature.
- Dense = darker.
Images:
Nephritic syndrome
Rapidly progressive glomerulonephritis
- Abbreviated RPGN.
- AKA crescentic glomerulonephritis.
General
- Acute renal dysfunction.
- Nephritic syndrome.
DDx:
- Linear immunofluorescence.
- Granular immunofluorescence
- Pauci-immune.
Microscopic
Features:
- Glomerular crescents.
- Interstitial inflammation.
- +/-Vasculitis.
Images
Post-infectious glomerulonephritis
- Abbreviated PIGN.
Rare diseases
Antiglomerular basement membrane disease
- Abbreviated AGBM.
General
- Known as Goodpasture disease (AKA Goodpasture syndrome), if renal failure is accompanied by pulmonary hemorrhage.[52]
- Rare - estimated incidence 1/1-2 million.[53]
- Antibody mediated hypersensitivity.
- Thought to occur in genetically susceptible individuals.[53]
- Associated with a specific HLA type (HLA-DRB1*1501) and two gene families.
- Antibodies directed against COL4A3,[54] which is not mutated.
- Oligouria - poor prognosticator.[citation needed]
Tx:
- Immune suppression & plasma exchange.[55]
Clinical DDx:
- Wegener granulomatosis.
- Azathioprine toxicity.[56]
Microscopic
Features:
- RPGN.
- Crescentic glomerulonephritis.
Images
www:
IF
- Linear IgG deposits - diagnostic.
- Fibrinogen in crescents.
DDx:
- Goodpasture syndrome with the pulmonary hemorrhage.
Image:
Thin glomerular basement membrane disease
General
- Collagen IV mutation - the same protein is involved in Alport syndrome.
Clinical:
- Hematuria.
- FHx.
- Nonprogressive.
Microscopic
- Normal.
IF
- Normal.
EM
- GBM thin <200-250 - key feature.
Note:
- Normal GBM: 300-350 nm.
Alport syndrome
General
Clinical:
- Hearing loss (sensorineural).
- Hematuria - usually preceeds hearing loss.[57]
- Can be thought of a pathologic form of thin basement membrane disease.[58]
Etiology:
- Genetic defect - collagen type IV.
Inheritance:[57]
- X-linked - 80%.
- Autosomal recessive - 15%.
- Autosomal dominant - 5%.
Microscopic
Features:[59]
- Usu. normal.
- +/-Foamy appearing renal tubular cells.[60]
IF
- Negative.
EM
Features:[59]
- Abnormal glomerular basement membrane (GBM); thinning or thickening.
- Classically thinning with thick lamellation (splitting/multi-layering).
Idiopathic nodular glomerulosclerosis
General
- Not diabetic - key feature.
Associations:[61]
- Smoking - common; thought to be important in the etiology.[62]
- Hypertension.
Microscopic
Features:[61]
- Looks like diabetic nodular glomerulosclerosis.
IF
Nonspecific.
EM
Nonspecific.
Fabry disease
Myeloma
- See: Haematopathology.
- AKA myeloma kidney.
Myeloma cast nephropathy
General
- Renal failure.
Microscopic
Features:[63]
- Crap in tubules, eosinophilic.
- Classically angulated.
- Refractile.
- Cast with cellular reaction - virtually diagnostic.
- Macrophages (CD68 +ve).
Images
www:
- Cast nephropathy in myeloma (kidneypathology.com).
- Cast nephropathy in myeloma - refractile crap (kidneypathology.com).
Stains
- Myeloma casts = PAS -ve.
- Hyaline casts = PAS +ve.
Amyloidosis
- Usually associated with lambda clone.
Light chain deposition
- Usually associated with kappa clone.
Immunotactoid glomerulopathy
General
- Uncommon.
- Thought to be a primary glomerulopathy.
- Must exclude lupus nephritis, paraproteinemias, fibrillary glomerulopathy, cryoglobulinemia, renal amyloidosis.
- "Not universally" considered distinct from fibrillary glomerulopathy.[64]
Presentation:
- Nephrotic range proteinuria ~ 60% of cases.[65]
- Hypertension.
Microscopic
Features:
- Mesangial expansion.
DDx:
- Other causes of mesangial expansion.
IHC
- Congo red stain -ve.
Fibrillary glomerulonephritis
- AKA fibrillary glomerulopathy.
General
- Rare ~ 1% native kidney biopsies.[64]
- Presents as nephrotic syndrome.
- Prognosis poor; large number progress to ESRD.
Microscopic
Features:
- Mesangial matrix expansion.
- Thickened capillary walls.
Images:
IF
- IgG predominant.[64]
Stains
- Congo red stain -ve.
EM
- Fibrils:[64]
- Non-branching.
- Randomly arranged.
- Usu. 18-20 nm in diameter -- larger than amyloid (see below).
- Size range 12-24 nm.
Note:
Aristolochic acid nephropathy
General
- Nephropathy due to chinese herbs for slimming.[68]
- Associated with urothelial atypia/urothelial carcinoma.
Clinical:
- Chinese herb use.
- Low-molecular weight proteinuria.
Microscopic
Features:[68]
- Extensive interstitial fibrosis.
- Tubular atrophy - typically greater in outer cortex than inner cortex.
- Glomeruli spared.
- +/-Nuclear atypia of the urothelium.
DDx:
- Balkan endemic nephropathy.
Image:
Cystic kidney diseases
These are discussed in a separate article and include:
- Autosomal dominant polycystic kidney disease (ADPKD).
- Adult-onset medullary cystic disease.
- Acquired renal cystic disease.
- Autosomal recessive polycystic kidney disease (ARPKD).
- Medullary sponge kidney.
- Nephronophthisis.
- Cystic renal cell carcinoma.
Pyelonephritis
Pyelonephritis is a misnomer; it is not an inflammatory process affecting the renal pelvis, as the name suggests. Pyelonephritis actually refers to a nephritis or tubulointerstitial nephritis.[69]
It can be subdivided into:
Acute pyelonephritis
General
- Typically preceeded by a (lower) urinary tract infection (UTI).
- Usually diagnosed clinically:
- Urine C&S, urine R&M, +/-CT abdomen.
- Fever, costovertebral tenderness.
Gross
Features:
Microscopic
Features:
- Neutrophils within the renal tubules and interstitium.[71]
Images
Chronic pyelonephritis
- Reflux nephropathy is considered synonym in some sources.[72]
General
- Inflammation of the kidney (nephritis) and renal pelvis (pyelo-[73]).
- May be associated with vesicoureteral reflux.
- Chronic pyelonephritis may be a reason for nephrectomy.[74]
Gross
Microscopic
Features:[75]
- Mononuclear tubulointerstitial infiltrate.
- Usu. more dense at the pelvis.
- Interstitial fibrosis.
- +/-Renal casts (PAS positive); may result in a thyroid-like apparance.
DDx:
Stains
- PAS +ve -- renal tubular casts.
Disease that does not commonly get biopsied
End-stage kidney
Malignant hypertension
- May be seen in scleroderma.
Acute tubular necrosis
- Often abbreviated ATN.
General
Diagnosed clinically:
- Using urine R&M - hemegranular casts[76] are diagnostic.
- Anuria or low urine output.
Gross
- Poorly defined corticomedullary junction - soft finding.
- Slightly heavier ~ 180 grams.[77]
Microscopic
Features:[77]
- Tubular epithelial whorls - present in approx. one third of cases - most important.
- Detached epithelium within the luminal space surrounded by epithelium.
- Similar to epithelial telescoping seen in endometrial biopsies.
- Detached epithelium within the luminal space surrounded by epithelium.
- Tubulorrhexis - present in approx. one third of cases.
- Disruption of the tubular basement membrane.
- Interstitial edema - sensitive... but not specific.
Notes - not particularily useful findings:
- Mitoses.
- Casts in tubules.
IHC
- Ki-67 - focal nuclear staining of the tubular epithelium.[77]
Hepatorenal syndrome
General
- Acute renal failure secondary to liver failure (e.g. fulminant liver failure, cirrhosis with marginal liver function).
Clinical:
- Urine sodium is low,[78] unlike in ATN (the main DDx).
Pathophysiology:
- Renal vasoconstriction.[79]
Treatment: Medical and surgical:[80]
- Vasoconstrictors (e.g. midodrine, terlipressin (counteracts splanchnic vasodilation), norepinephrine).
- Albumin.
- TIPS (transjugular intrahepatic portosystemic shunt).
- Liver transplantation.
Note:
- I suspect a portal vein pump would work... it reduces portal pressure and would likely increase hepatic function.
Microscopic
Features (kidney):
- Normal.
Nephrocalcinosis
General
Microscopic
Features:
- Calcification of the renal parenchyma - key feature.
Images:
Renal transplant pathology
- Acute rejection.
- Chronic rejection.
- Polyomavirus.
- Transplant glomerulopathy.
- Calcineurin-inhibitor toxicity.
See also
References
- ↑ Mendelssohn DC, Barrett BJ, Brownscombe LM, et al. (August 1999). "Elevated levels of serum creatinine: recommendations for management and referral". CMAJ 161 (4): 413–7. PMC 1230545. PMID 10478168. http://www.cmaj.ca/cgi/content/full/161/4/413.
- ↑ URL: http://www.nlm.nih.gov/medlineplus/ency/article/003475.htm. Accessed on: 8 November 2010.
- ↑ URL: http://www.sydpath.stvincents.com.au/other/Conversions/ConversionMasterF3.htm. Accessed on: 8 November 2010.
- ↑ URL: http://www.unc.edu/~rowlett/units/scales/clinical_data.html. Accessed on: 8 November 2010.
- ↑ URL: http://www.kidney.org/professionals/KLS/gfr.cfm. Accessed on: 8 November 2010.
- ↑ Ruggenenti P, Gaspari F, Perna A, Remuzzi G (February 1998). "Cross sectional longitudinal study of spot morning urine protein:creatinine ratio, 24 hour urine protein excretion rate, glomerular filtration rate, and end stage renal failure in chronic renal disease in patients without diabetes". BMJ 316 (7130): 504–9. PMC 2665663. PMID 9501711. http://www.ncbi.nlm.nih.gov/pmc/articles/PMC2665663/pdf/9501711.pdf.
- ↑ URL: http://www.fpnotebook.com/urology/lab/urnprtntcrtnrt.htm. Accessed on: 8 November 2010.
- ↑ Levo Y, Pick AI (1974). "The significance of C3 and C4 complement levels in lupus nephritis". Int Urol Nephrol 6 (3-4): 233–8. PMID 4549215. http://www.springerlink.com/content/l1657797661468g1/fulltext.pdf.
- ↑ 9.0 9.1 Nusinow SR, Zuraw BL, Curd JG (May 1985). "The hereditary and acquired deficiencies of complement". Med. Clin. North Am. 69 (3): 487–504. PMID 3892188.
- ↑ URL: beckmancoulter.com. Accessed on: 9 November 2010.
- ↑ URL: beckmancoulter.com. Accessed on: 9 November 2010.
- ↑ Kallenberg, CG. (Mar 2011). "Pathogenesis of ANCA-associated vasculitides.". Ann Rheum Dis 70 Suppl 1: i59-63. doi:10.1136/ard.2010.138024. PMID 21339221.
- ↑ Guzman, RP.; Zierler, RE.; Isaacson, JA.; Bergelin, RO.; Strandness, DE. (Mar 1994). "Renal atrophy and arterial stenosis. A prospective study with duplex ultrasound.". Hypertension 23 (3): 346-50. PMID 8125561.
- ↑ URL: http://www.nlm.nih.gov/medlineplus/ency/article/003586.htm. Accessed on: 20 September 2010.
- ↑ URL: http://emedicine.medscape.com/article/238158-overview. Accessed on: 9 November 2010.
- ↑ URL: http://www.nephrologychannel.com/agn/index.shtml. Accessed on: 9 November 2010.
- ↑ URL: http://books.google.com/books?id=5bmg8xiLxkMC&pg=PA249&lpg=PA249&dq=Nephritic+syndrome+PHAROH#v=onepage&q=Nephritic%20syndrome%20PHAROH&f=false. Accessed on: 9 December 2009.
- ↑ URL: http://www.emedicine.com/med/topic886.htm and http://www.emedicine.com/ped/topic1564.htm. Accessed on: 8 November 2010.
- ↑ 19.0 19.1 Kim, BS.; Kim, YK.; Shin, YS.; Kim, YO.; Song, HC.; Kim, YS.; Choi, EJ. (Dec 2009). "Natural history and renal pathology in patients with isolated microscopic hematuria.". Korean J Intern Med 24 (4): 356-61. doi:10.3904/kjim.2009.24.4.356. PMID 19949735.
- ↑ URL: http://bestpractice.bmj.com/best-practice/monograph/207/basics/classification.html. Accessed on: 17 November 2011.
- ↑ Cotran, Ramzi S.; Kumar, Vinay; Fausto, Nelson; Nelso Fausto; Robbins, Stanley L.; Abbas, Abul K. (2005). Robbins and Cotran pathologic basis of disease (7th ed.). St. Louis, Mo: Elsevier Saunders. pp. 956. ISBN 0-7216-0187-1.
- ↑ Hoy, WE.; Douglas-Denton, RN.; Hughson, MD.; Cass, A.; Johnson, K.; Bertram, JF. (Feb 2003). "A stereological study of glomerular number and volume: preliminary findings in a multiracial study of kidneys at autopsy.". Kidney Int Suppl (83): S31-7. PMID 12864872. http://www.nature.com/ki/journal/v63/n83s/fig_tab/4493733t2.html#figure-title.
- ↑ Nyengaard, JR.; Bendtsen, TF. (Feb 1992). "Glomerular number and size in relation to age, kidney weight, and body surface in normal man.". Anat Rec 232 (2): 194-201. doi:10.1002/ar.1092320205. PMID 1546799.
- ↑ Grcevska, L.; Ristovska, V.; Nikolov, V.; Petrusevska, G.; Milovanceva-Popovska, M.; Polenakovic, M. (Dec 2010). "The Oxford classification of IgA nephropathy: single centre experience.". Prilozi 31 (2): 7-16. PMID 21258273.
- ↑ Jothy, S.; Sawka, RJ. (Nov 1981). "Presence of monocytes in systemic lupus erythematosus-associated glomerulonephritis: marker study and significance.". Arch Pathol Lab Med 105 (11): 590-3. PMID 6975091.
- ↑ AH. 13 August 2009.
- ↑ Fogo, Agnes B.; Kashgarian, Michael (2005). Diagnostic Atlas of Renal Pathology: A Companion to Brenner and Rector's The Kidney 7E (1st ed.). Saunders. pp. 16. ISBN 978-1416028710.
- ↑ 28.0 28.1 Fogo, Agnes B.; Kashgarian, Michael (2005). Diagnostic Atlas of Renal Pathology: A Companion to Brenner and Rector's The Kidney 7E (1st ed.). Saunders. pp. 7. ISBN 978-1416028710.
- ↑ Berden, AE.; Ferrario, F.; Hagen, EC.; Jayne, DR.; Jennette, JC.; Joh, K.; Neumann, I.; Noël, LH. et al. (Oct 2010). "Histopathologic classification of ANCA-associated glomerulonephritis.". J Am Soc Nephrol 21 (10): 1628-36. doi:10.1681/ASN.2010050477. PMID 20616173. http://jasn.asnjournals.org/content/21/10/1628/T1.expansion.html.
- ↑ AH. 17 July 2009.
- ↑ Fioretto P, Mauer M (March 2007). "Histopathology of diabetic nephropathy". Semin. Nephrol. 27 (2): 195-207. doi:10.1016/j.semnephrol.2007.01.012. PMID 17418688.
- ↑ URL: http://path.upmc.edu/cases/case51/dx.html. Accessed on: 9 November 2010.
- ↑ 33.0 33.1 33.2 Smet, AD.; Kuypers, D.; Evenepoel, P.; Maes, B.; Messiaen, T.; Van Damme, B.; Vanrenterghem, Y. (Nov 2001). "'Full house' positive immunohistochemical membranoproliferative glomerulonephritis in a patient with portosystemic shunt.". Nephrol Dial Transplant 16 (11): 2258-62. PMID 11682680.
- ↑ Zelmanovitz T, Gerchman F, Balthazar AP, Thomazelli FC, Matos JD, Canani LH (2009). "Diabetic nephropathy". Diabetol Metab Syndr 1 (1): 10. doi:10.1186/1758-5996-1-10. PMC 2761852. PMID 19825147. https://www.ncbi.nlm.nih.gov/pmc/articles/PMC2761852/.
- ↑ Østerby R, Hartmann A, Bangstad HJ (April 2002). "Structural changes in renal arterioles in Type I diabetic patients". Diabetologia 45 (4): 542–9. doi:10.1007/s00125-002-0780-2. PMID 12032631.
- ↑ Ritchie S, Waugh D (1957). "The pathology of Armanni-Ebstein diabetic nephropathy". Am. J. Pathol. 33 (6): 1035–57. PMC 1934668. PMID 13478656. http://www.ncbi.nlm.nih.gov/pmc/articles/PMC1934668/?page=1.
- ↑ Zhou C, Byard RW (September 2010). "Armanni-Ebstein phenomenon and hypothermia". Forensic Sci Int. doi:10.1016/j.forsciint.2010.08.018. PMID 20875709.
- ↑ 38.0 38.1 URL: http://www.ndt-educational.org/ferrariodiabete.asp. Accessed on: 29 April 2012.
- ↑ Stout LC, Whorton EB (August 2007). "Pathogenesis of extra efferent vessel development in diabetic glomeruli". Hum. Pathol. 38 (8): 1167–77. doi:10.1016/j.humpath.2007.01.019. PMID 17490718.
- ↑ Tervaert, TW.; Mooyaart, AL.; Amann, K.; Cohen, AH.; Cook, HT.; Drachenberg, CB.; Ferrario, F.; Fogo, AB. et al. (Apr 2010). "Pathologic classification of diabetic nephropathy.". J Am Soc Nephrol 21 (4): 556-63. doi:10.1681/ASN.2010010010. PMID 20167701.
- ↑ Weening JJ, D'Agati VD, Schwartz MM, et al. (February 2004). "The classification of glomerulonephritis in systemic lupus erythematosus revisited". J. Am. Soc. Nephrol. 15 (2): 241–50. PMID 14747370. http://www.nature.com/ki/journal/v55/n2/full/4490631a.html.
- ↑ URL: http://www.med.niigata-u.ac.jp/npa/Lectures/Lupus_Nephritis.htm. Accessed on: 9 November 2010.
- ↑ Wei, Q.; Zhang, L.; Liu, X. (Feb 2011). "Outcome of severe preeclampsia manifested as nephrotic syndrome.". Arch Gynecol Obstet 283 (2): 201-4. doi:10.1007/s00404-009-1338-z. PMID 20033418.
- ↑ Smerud, HK.; Fellström, B.; Hällgren, R.; Osagie, S.; Venge, P.; Kristjánsson, G. (Aug 2009). "Gluten sensitivity in patients with IgA nephropathy.". Nephrol Dial Transplant 24 (8): 2476-81. doi:10.1093/ndt/gfp133. PMID 19332868.
- ↑ Komatsuda, A.; Wakui, H.; Yasuda, T.; Imai, H.; Miura, AB.; Tsuda, A.; Nakamoto, Y. (Nov 1994). "Successful delivery in a pregnant women with crescentic IgA nephropathy.". Intern Med 33 (11): 723-6. PMID 7849391.
- ↑ Kim, JK.; Kim, JH.; Lee, SC.; Kang, EW.; Chang, TI.; Moon, SJ.; Yoon, SY.; Yoo, TH. et al. (Mar 2012). "Clinical features and outcomes of IgA nephropathy with nephrotic syndrome.". Clin J Am Soc Nephrol 7 (3): 427-36. doi:10.2215/CJN.04820511. PMID 22322610.
- ↑ Coppo, R.; Cattran, D.; Roberts Ian, SD.; Troyanov, S.; Camilla, R.; Cook, T.; Feehally, J. (Jul 2010). "The new Oxford Clinico-Pathological Classification of IgA nephropathy.". Prilozi 31 (1): 241-8. PMID 20693944.
- ↑ 48.0 48.1 Pakasa, NM.; Binda, PM. (Jul 2011). "HIV-associated immune complex glomerulonephritis with lupus-like features.". Saudi J Kidney Dis Transpl 22 (4): 769-73. PMID 21743226.
- ↑ Sethi, S.; Fervenza, FC. (Jul 2011). "Membranoproliferative glomerulonephritis: pathogenetic heterogeneity and proposal for a new classification.". Semin Nephrol 31 (4): 341-8. doi:10.1016/j.semnephrol.2011.06.005. PMID 21839367.
- ↑ Sato, H. (Sep 1990). "[Ultrastructural study on membranoproliferative glomerulonephritis with special reference to subepithelial deposits].". Nihon Jinzo Gakkai Shi 32 (9): 973-83. PMID 2263028.
- ↑ 51.0 51.1 51.2 Walker, PD.; Ferrario, F.; Joh, K.; Bonsib, SM. (Jun 2007). "Dense deposit disease is not a membranoproliferative glomerulonephritis.". Mod Pathol 20 (6): 605-16. doi:10.1038/modpathol.3800773. PMID 17396142.
- ↑ Goodpasture EW (1919). "The significance of certain pulmonary lesions in relation to the etiology of influenza". Am J Med Sci 158 (6): 863–870. doi:10.1097/00000441-191911000-00012.
- ↑ 53.0 53.1 Zhou, XJ.; Lv, JC.; Zhao, MH.; Zhang, H. (2010). "Advances in the genetics of anti-glomerular basement membrane disease.". Am J Nephrol 32 (5): 482-90. doi:10.1159/000321324. PMID 20962523.
- ↑ Online 'Mendelian Inheritance in Man' (OMIM) 120070
- ↑ Shah, MK.; Hugghins, SY. (Dec 2002). "Characteristics and outcomes of patients with Goodpasture's syndrome.". South Med J 95 (12): 1411-8. PMID 12597309.
- ↑ Stetter, M.; Schmidl, M.; Krapf, R. (Jun 1994). "Azathioprine hypersensitivity mimicking Goodpasture's syndrome.". Am J Kidney Dis 23 (6): 874-7. PMID 8203372.
- ↑ 57.0 57.1 URL: http://emedicine.medscape.com/article/981126-overview
- ↑ AM. 13 August 2009.
- ↑ 59.0 59.1 Kashtan, CE. (Sep 1998). "Alport syndrome and thin glomerular basement membrane disease.". J Am Soc Nephrol 9 (9): 1736-50. PMID 9727383. http://jasn.asnjournals.org/content/9/9/1736.long.
- ↑ Klatt, Edward C. (2006). Robbins and Cotran Atlas of Pathology (1st ed.). Saunders. pp. 246. ISBN 978-1416002741.
- ↑ 61.0 61.1 Li, W.; Verani, RR. (Dec 2008). "Idiopathic nodular glomerulosclerosis: a clinicopathologic study of 15 cases.". Hum Pathol 39 (12): 1771-6. doi:10.1016/j.humpath.2008.05.004. PMID 18701135.
- ↑ Costa, AF.; Gomes dos Santos, WA.; Filho, MA.; Farias, FT.; Modesto dos Santos, V.. "Nodular glomerulosclerosis in a non-diabetic hypertensive smoker with dyslipidemia.". An Sist Sanit Navar 34 (2): 301-8. PMID 21904413.
- ↑ URL: http://www.kidneypathology.com/English_version/Amyloidosis_and_others.html. Accessed on: 9 November 2010.
- ↑ 64.0 64.1 64.2 64.3 64.4 64.5 Alpers, CE.; Kowalewska, J. (Jan 2008). "Fibrillary glomerulonephritis and immunotactoid glomerulopathy.". J Am Soc Nephrol 19 (1): 34-7. doi:10.1681/ASN.2007070757. PMID 18045849.
- ↑ Korbet, SM.; Schwartz, MM.; Lewis, EJ. (Mar 1991). "Immunotactoid glomerulopathy.". Am J Kidney Dis 17 (3): 247-57. PMID 1996564.
- ↑ Yang, L.; Su, T.; Li, XM.; Wang, X.; Cai, SQ.; Meng, LQ.; Zou, WZ.; Wang, HY. (Jun 2011). "Aristolochic acid nephropathy: variation in presentation and prognosis.". Nephrol Dial Transplant. doi:10.1093/ndt/gfr291. PMID 21719716.
- ↑ 67.0 67.1 URL: http://www.uninet.edu/cin2003/conf/cosyns/cosyns.html. Accessed on: 23 November 2011.
- ↑ 68.0 68.1 Reginster, F.; Jadoul, M.; van Ypersele de Strihou, C. (Jan 1997). "Chinese herbs nephropathy presentation, natural history and fate after transplantation.". Nephrol Dial Transplant 12 (1): 81-6. PMID 9027778. http://ndt.oxfordjournals.org/content/12/1/81.
- ↑ Mills, Stacey E; Carter, Darryl; Greenson, Joel K; Reuter, Victor E; Stoler, Mark H (2009). Sternberg's Diagnostic Surgical Pathology (5th ed.). Lippincott Williams & Wilkins. pp. 1725. ISBN 978-0781779425.
- ↑ 70.0 70.1 Klatt, Edward C. (2006). Robbins and Cotran Atlas of Pathology (1st ed.). Saunders. pp. 251. ISBN 978-1416002741.
- ↑ Mills, Stacey E; Carter, Darryl; Greenson, Joel K; Reuter, Victor E; Stoler, Mark H (2009). Sternberg's Diagnostic Surgical Pathology (5th ed.). Lippincott Williams & Wilkins. pp. 1726. ISBN 978-0781779425.
- ↑ Mills, Stacey E; Carter, Darryl; Greenson, Joel K; Reuter, Victor E; Stoler, Mark H (2009). Sternberg's Diagnostic Surgical Pathology (5th ed.). Lippincott Williams & Wilkins. pp. 1728. ISBN 978-0781779425.
- ↑ URL: http://medical-dictionary.thefreedictionary.com/pyelo-. Accessed on: 5 June 2015.
- ↑ URL: https://secure.health.utas.edu.au/intranet/cds/pathprac/Files/Cases/Renal/Case44/Case44.htm. Accessed on: 26 July 2011.
- ↑ 75.0 75.1 Mills, Stacey E; Carter, Darryl; Greenson, Joel K; Reuter, Victor E; Stoler, Mark H (2009). Sternberg's Diagnostic Surgical Pathology (5th ed.). Lippincott Williams & Wilkins. pp. 1729. ISBN 978-0781779425.
- ↑ Kanbay, M.; Kasapoglu, B.; Perazella, MA. (Jun 2010). "Acute tubular necrosis and pre-renal acute kidney injury: utility of urine microscopy in their evaluation- a systematic review.". Int Urol Nephrol 42 (2): 425-33. doi:10.1007/s11255-009-9673-3. PMID 19921458.
- ↑ 77.0 77.1 77.2 Kocovski, L.; Duflou, J. (Mar 2009). "Can renal acute tubular necrosis be differentiated from autolysis at autopsy?". J Forensic Sci 54 (2): 439-42. doi:10.1111/j.1556-4029.2008.00956.x. PMID 19207286.
- ↑ Epstein M, Oster JR, de Velasco RE (March 1976). "Hepatorenal syndrome following hemihepatectomy". Clin. Nephrol. 5 (3): 129-33. PMID 1261103.
- ↑ Angeli P, Merkel C (2008). "Pathogenesis and management of hepatorenal syndrome in patients with cirrhosis". J. Hepatol. 48 Suppl 1: S93-103. doi:10.1016/j.jhep.2008.01.010. PMID 18304678.
- ↑ Wong F (February 2008). "Hepatorenal syndrome: current management". Curr Gastroenterol Rep 10 (1): 22-9. PMID 18417039.